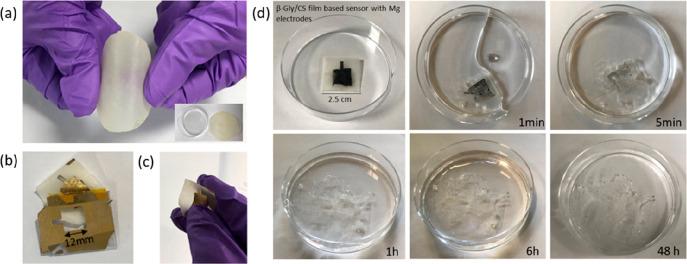
https://cdn.ncbi.nlm.nih.gov/pmc/blobs/4d84/8022537/2e71e6a47155/mt0c01139_0013.jpg

可生物降解材料在可持续健康监测设备中的应用
Biodegradable Materials for Sustainable Health Monitoring Devices.
机构信息
Bendable Electronics and Sensing Technologies (BEST) Group, James Watt School of Engineering, University of Glasgow, G12 8QQ Glasgow, U.K.
出版信息
ACS Appl Bio Mater. 2021 Jan 18;4(1):163-194. doi: 10.1021/acsabm.0c01139. Epub 2020 Dec 23.
The recent advent of biodegradable materials has offered huge opportunity to transform healthcare technologies by enabling sensors that degrade naturally after use. The implantable electronic systems made from such materials eliminate the need for extraction or reoperation, minimize chronic inflammatory responses, and hence offer attractive propositions for future biomedical technology. The eco-friendly sensor systems developed from degradable materials could also help mitigate some of the major environmental issues by reducing the volume of electronic or medical waste produced and, in turn, the carbon footprint. With this background, herein we present a comprehensive overview of the structural and functional biodegradable materials that have been used for various biodegradable or bioresorbable electronic devices. The discussion focuses on the dissolution rates and degradation mechanisms of materials such as natural and synthetic polymers, organic or inorganic semiconductors, and hydrolyzable metals. The recent trend and examples of biodegradable or bioresorbable materials-based sensors for body monitoring, diagnostic, and medical therapeutic applications are also presented. Lastly, key technological challenges are discussed for clinical application of biodegradable sensors, particularly for implantable devices with wireless data and power transfer. Promising perspectives for the advancement of future generation of biodegradable sensor systems are also presented.
最近可生物降解材料的出现为医疗技术带来了巨大的变革机会,因为它可以使使用后自然降解的传感器成为可能。由这些材料制成的可植入电子系统消除了提取或再次手术的需要,最大限度地减少了慢性炎症反应,因此为未来的生物医学技术提供了极具吸引力的方案。由可降解材料开发的环保型传感器系统还可以通过减少电子或医疗废物的产生量,从而减少碳足迹,帮助缓解一些重大的环境问题。有鉴于此,本文全面概述了用于各种可生物降解或可生物吸收电子设备的结构和功能可生物降解材料。讨论的重点是天然和合成聚合物、有机或无机半导体以及可水解金属等材料的溶解速率和降解机制。本文还介绍了用于身体监测、诊断和医疗治疗应用的基于可生物降解或可生物吸收材料的传感器的最新趋势和实例。最后,还讨论了可生物降解传感器临床应用的关键技术挑战,特别是对于具有无线数据和电源传输功能的植入式设备。本文还提出了未来可生物降解传感器系统发展的有前景的观点。